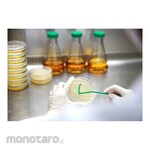
SPL Life Sciences L-Spreader

Beli spreader di monotaro.id
Kami Menampilkan Rekomendasi Kami Untuk Anda! Anda Bisa Membelinya Kapan Saja di monotaro.id
- WESTWARD Broadcast Spreaderatribut:
- Product Type: Broadcast Spreader
- Drop Type: 1 Hole
- Hopper Material: Polypropylene
- Wheel Type: Pneumatic
- Ningbo Ha Glass Bacterial Cell SpreaderDeskripsi:Glass Bacterial Cell Spreader with triangular endatribut:
- Blade Width (mm): 35-40
- Length of Handle (cm): 16
- Diameter Rod (mm): 5
- Material: Glass
- SUN RUN Hydraulic Flange SpreaderDeskripsi:SWR-40 Hydraulic Spreader-Only requests an access gap of 0.24inch (6mm)-Automatic mechanical retraction-Unique interlocking : no first step bending and risk of slipping out of jointatribut:
- Max. Spread force (kN): 125
- Tip Clearance (mm): 6
- Max. Spread (mm): 81
- Oil Capacity (cc): 78
- Delta Cell Spreaderatribut:
- Sterility: sterile
- SizexWidthxthickness (mm): 172x37x4
- SPL Life Sciences Loop and Needle SterileDeskripsi:Loop & Needle Disposable Loop and Needle consists of a loop on one side and a needle on the other, used for the inoculatin of microorganisms. Two different sizes are available. ▪ For microbe inoculation ▪ Dual purpose : a loop on one end and needle on the other▪ Color coded for sizes (White for 1㎕, Blue for 10 ㎕)▪ DNase / RNase – free▪ Human DNA – freeatribut:
- Length(mm): 195
- Material: PP
- Sterile: +
- Packaging: 10/500
- SPL Life Sciences L-SpreaderDeskripsi:Spreader Disposable spreader is used for spreading microorganisms, which is sterilized before the release. ¿ For the spreading of microbe samples¿ Autoclavable¿ DNase / RNase – free¿ Human DNA – freeatribut:
- Material: PP
- Sterile: +
- Packaging: 10/500
- METALFAR Slip On Flange 304/L RF 150# 1" MFFatribut:
- Material: 304/L
- Size (inch): 1
- Class: 150#
- Sanplatec Cell spreaderDeskripsi:Disposable cell spreader. This is a cost-effective product. Can be used with confidence because it is sterilized by gamma rays. All products are individually packaged. Since it is made of Polypropylene, autoclaving is possible. Long handle part reduces contamination risk.atribut:
- Dimensions (WxHxL) (mm): 305x109x403
- Material: PP (Polypropylene)
- Length (mm): 215
- Width (mm): 30
- Color: blue
- Labware Charuzu Inoculation LoopDeskripsi:Ultra smooth loop made from high grade polystyrene ergonomic design easy to handle and orientating loop head
- DURAN Bottle Laboratory with Screw Cap (Botol Lab)Deskripsi:1. complies with the standards in ISO 4796-1:2016 Laboratory glassware2. Manufactured from DURAN® borosilicate glass 3.3. DURAN®
- WESTWARD Handheld Broadcast SpreaderDeskripsi:Grainger hand spreaders are reliable, consistent and built for a variety of lawn care needs. These broadcast spreaders can easily handle projects such as fertilizing your small personal garden, spot-planting grass seed or salting iced-over walkways and driveways. Let Grainger help you get the job done quickly and easily with convenient handheld broadcast spreaders.atribut:
- Features: Easy-Crank Design; Lightweight
- Product Type: Handheld Broadcast Spreader
- Handle: Hand Crank
- Drop Type: Broadcast
- Hopper Material: Polypropylene
- Capacity (lbs): 3.3
- For use with: Fertilizer; Salt; Seed
- Spread Width (ft): 5 to 12
- UNSPSC: 21101804
- WESTWARD Ball Pein HammerDeskripsi:Standard ball-peen hammers strike objects and shape material in everyday applications where a non-sparking hammer isn't needed. Their peened face is rounded to curve the edges of fasteners and to shape metal without creasing it.atribut:
- Hammer Type: Ball Pein Hammer
- Head Material: Steel
- Non-Sparking: No
- UNSPSC: 27111602
- WESTWARD Infrared ThermometerDeskripsi:Westward infrared thermometers use laser sighting to measure surface temperatures of objects that are out of reach such as HVAC equipment or automotive systems.atribut:
- Item - Infrared Thermometer: Infrared Thermometer
- Calibration Certificate Included: No
- Data Logging - Instrument: No
- UNSPSC: 41112210
- Enerpac Cordless Pump Kit, 4/3 Man. Valve, 230V Charger #Deskripsi:Product Lines : Industrial ToolsThe XC-Series cordless pump is ideal for jobs that require a combination of portability, speed, and safety. These cordless pumps are perfect for remote locations without access to power, but also indoors where trip hazards, ergonomics or size is a concern. The XC-Series cordless pump is compatible with all Enerpac hydraulic tools and small to medium sized cylinders.Lightweight design with integrated handle and carrying strap for portabilityBladder reservoir prevents contamination and allows pump usage in any positionPowerful ½ horsepower motor and 28 volt Lithium-Ion battery deliver exceptional speed and run timeHigh-strength fiberglass reinforced composite shroud for superior durability in demanding job site environmentsCordless technology eliminates tripping hazards found in other electric or air powered pumpsThe Lithium-Ion battery provides superior run time, even under extreme job site conditions.*- 279 cuts of 3/8 inch reinforcing bar using the WHC750 Cutter- 112 lifts with the WR5 Spreader- 44 splits on 1-inch, grade 8 nuts using the NC3241 Nut Splitter- 28 lifts of an RC104*Actual number of cycles per charge will vary depending on condition of tool, battery and ambient conditions. Battery life with double-acting tools is approximately 75% of that for comparable, single-acting tools.The XC-Series cordless pump is CSA and CE compliantatribut:
- Maximum Operating Pressure (bar): 700
- Cylinder Compatability: Double-acting
- Maximum Flow at Rated Pressure (L/minute): 0.25
- Output Flow Rate No-load (L/minute): 2.0
- Charger Voltage (V): AC 115
- Duty cycle: Intermittent
- Motor Size (Hp): 0.5
- Number of Outlets: 2
- Output Flow Rate (L/minute): 0.50 at 140bar, 0.25 at 700bar
- Output Flow Rate Load (L/minute): 0.25
- Power Source: Battery
- Valve Function: Advance / Neutral / Retract
- Valve Operation: Manual
- Valve Type: 4-way, 3-position
- SUN RUN Electric Pump (Pompa Elektrik)Deskripsi:SPE-2Hydraulic Electric Pump-Two stage models for reduced cycle times and improved productivity-Easy to customize with modular accessory kits-User adjustable external relief valve with a factory set upper limit prevents system overload-Easy to read integrated oil level sight glass-Totally enclossed fan-cooled motors are ideal for outdoor use in many environments
- JETJO TOOLS Mata Kunci Sok 1/4inch 6 ptatribut:
- Material: CRV Steel
Daftar Harga spreader Terbaru March 2026
| WESTWARD Broadcast Spreader | Rp3.399.900 |
| Ningbo Ha Glass Bacterial Cell Spreader | Rp269.900 |
| SUN RUN Hydraulic Flange Spreader | Rp39.999.900 |
| Delta Cell Spreader | Rp3.899.900 |
| SPL Life Sciences Loop and Needle Sterile | Rp56.900 |
| TORA Puller Bearing | Rp199.900 |
| SPL Life Sciences L-Spreader | Rp70.900 |
| OTC Oil Filter Wrench | Rp1.199.900 |
| METALFAR Slip On Flange 304/L RF 150# 1" MFF | Rp329.900 |
| Sanplatec Cell spreader | Rp779.900 |
Data diperbarui pada 12/03/2026 (Harga belum termasuk PPN)

/aqP103203386-2.jpg)





/P103055275-1.jpg)
